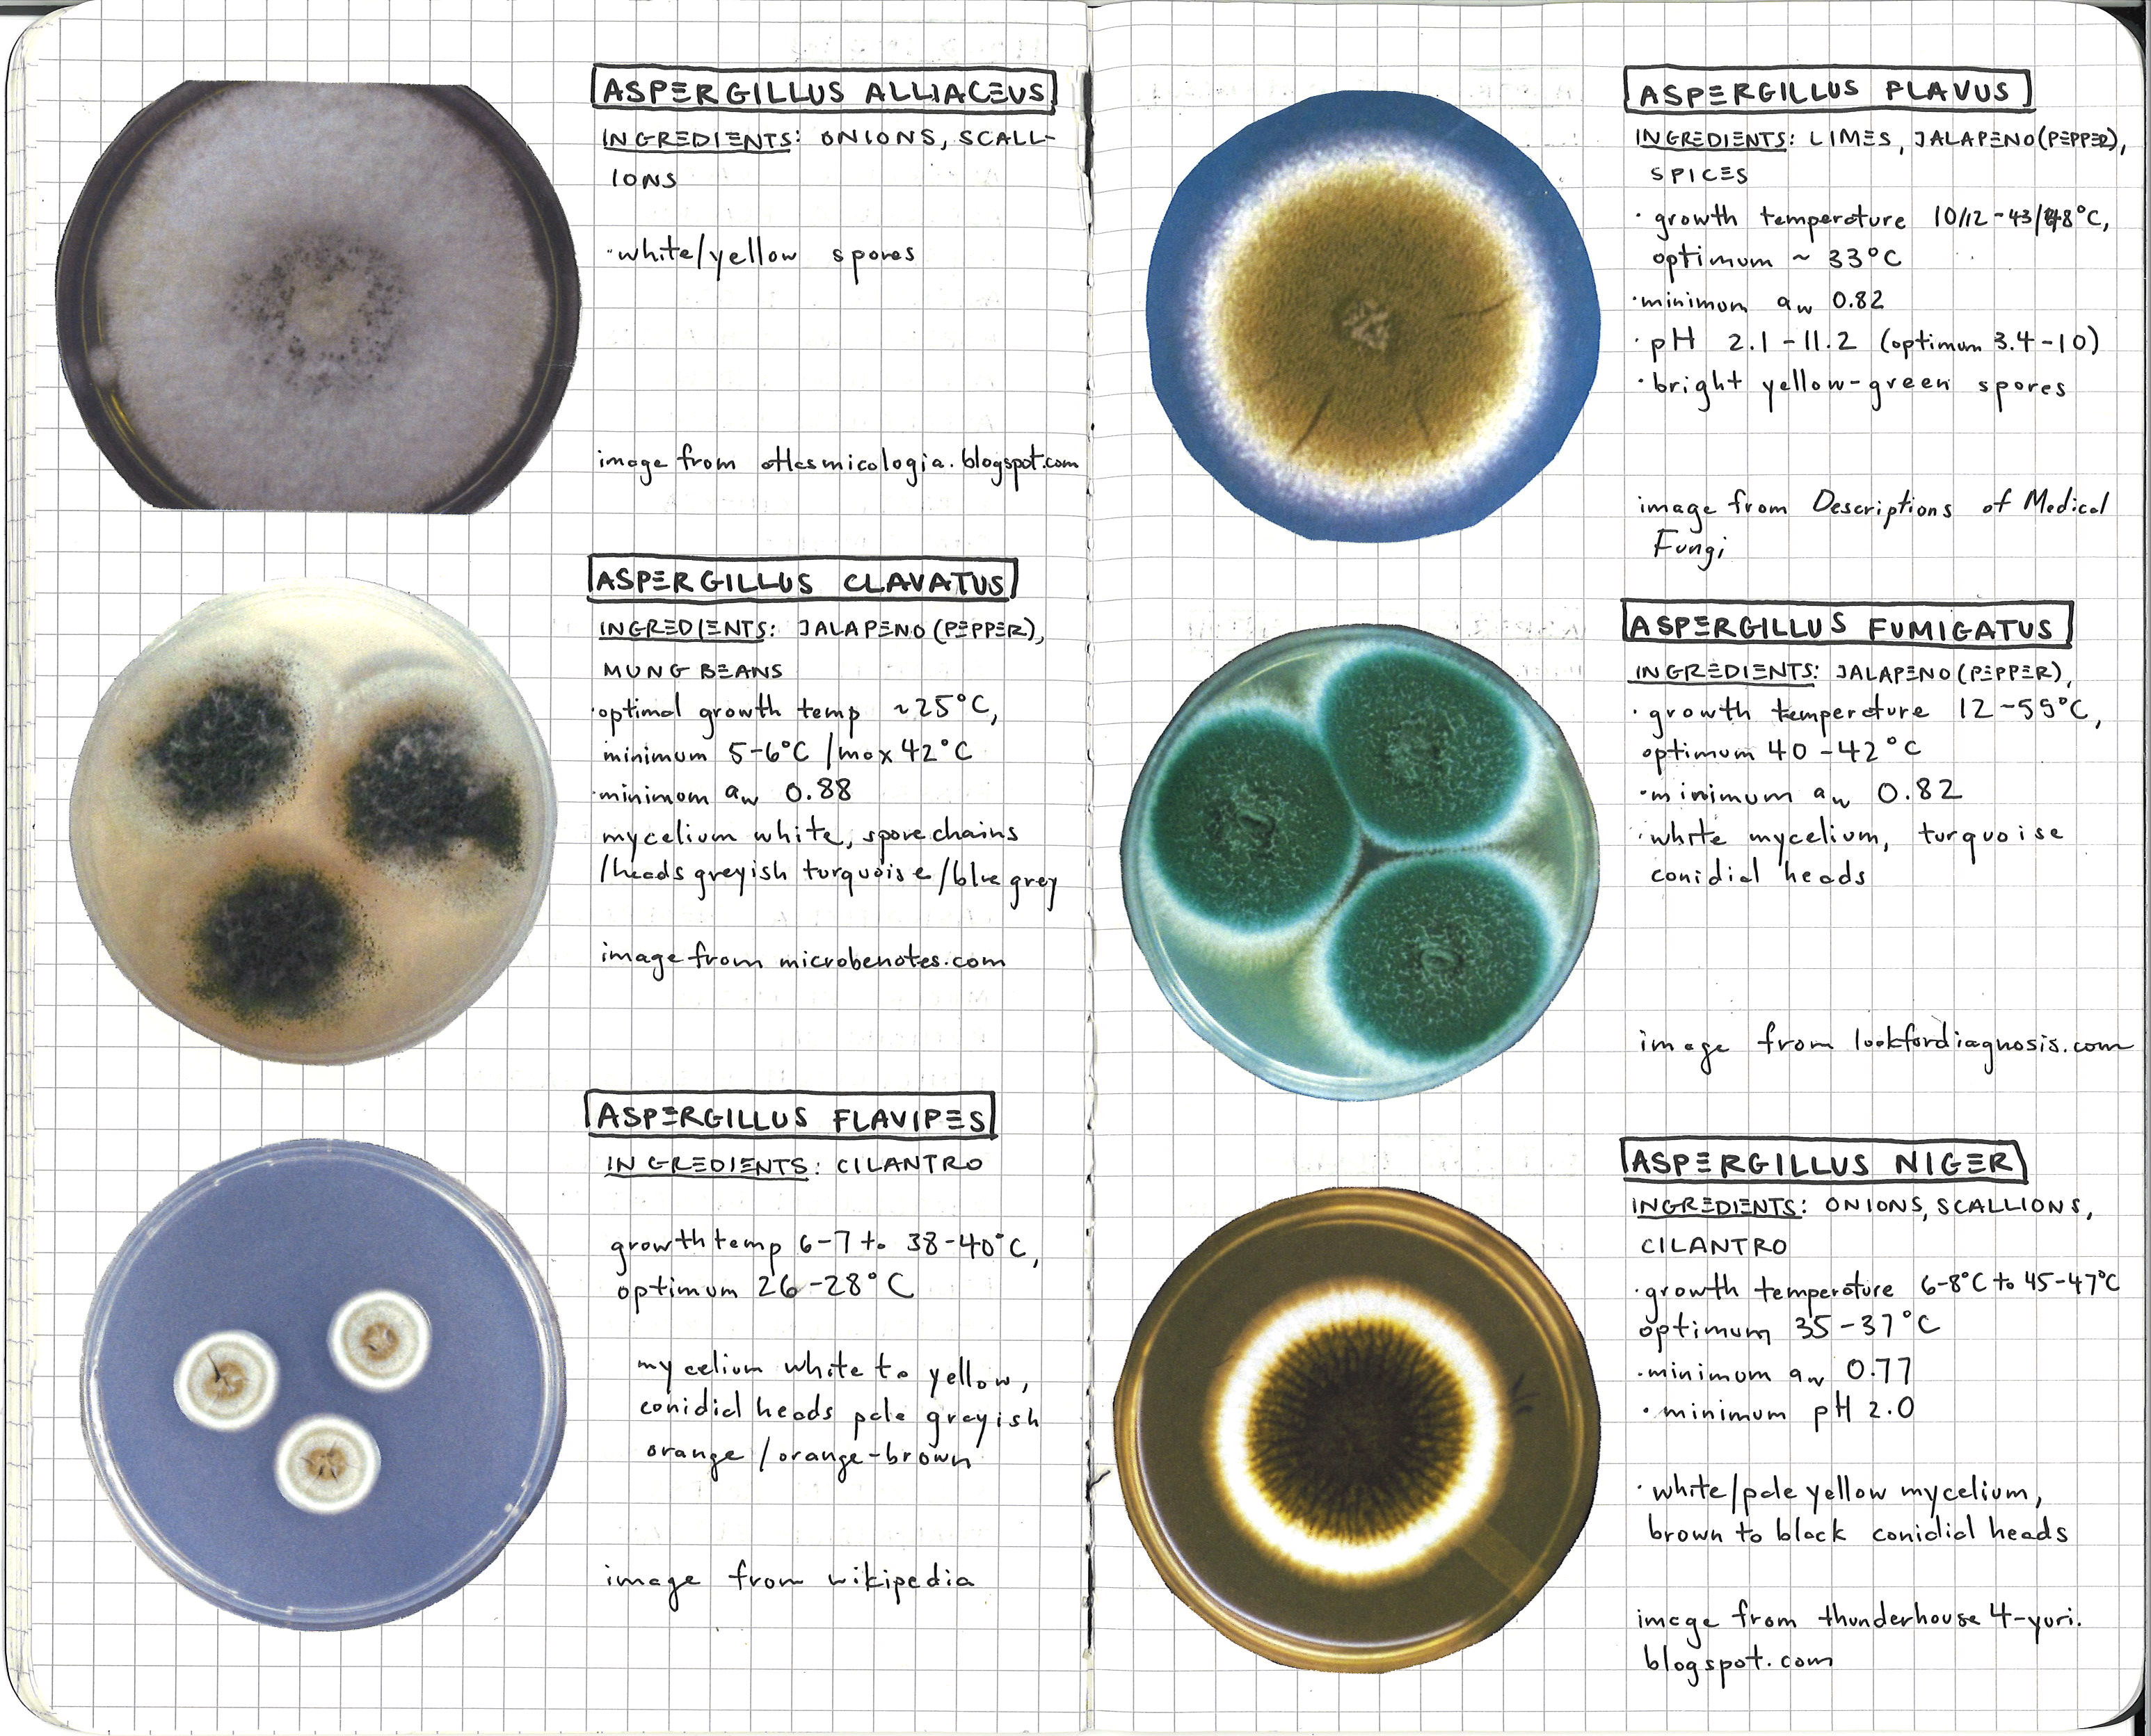
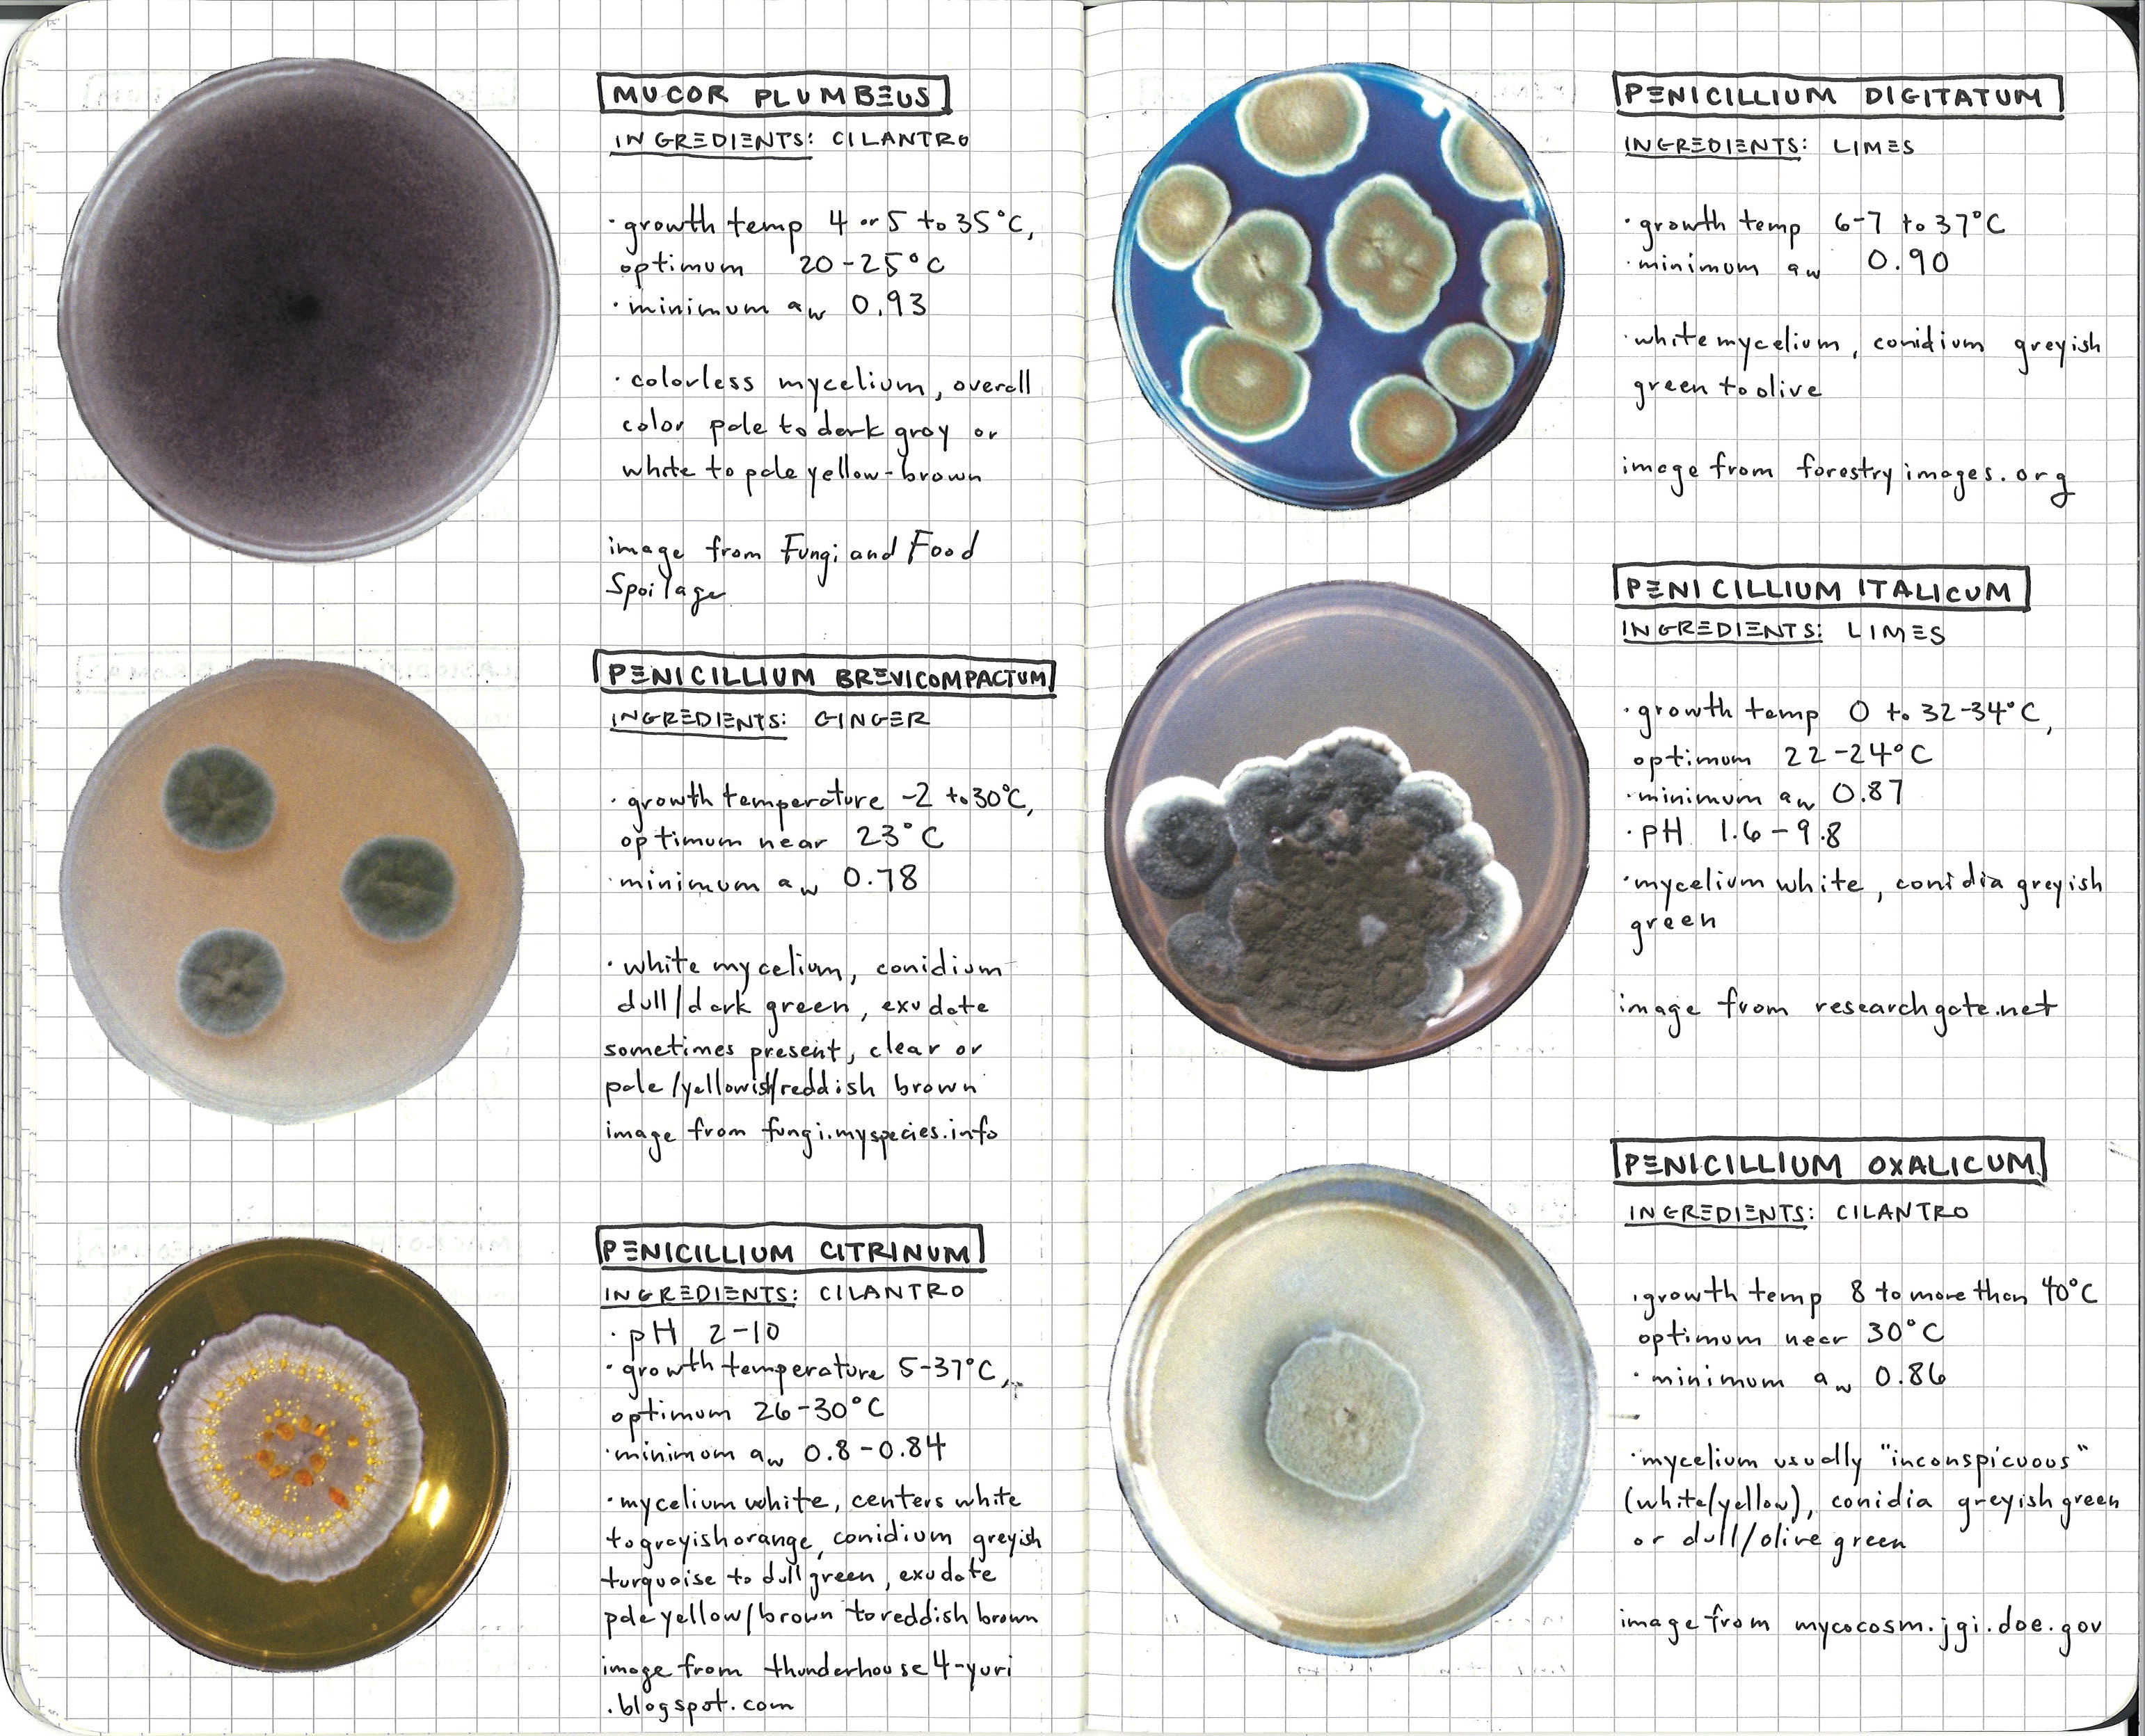
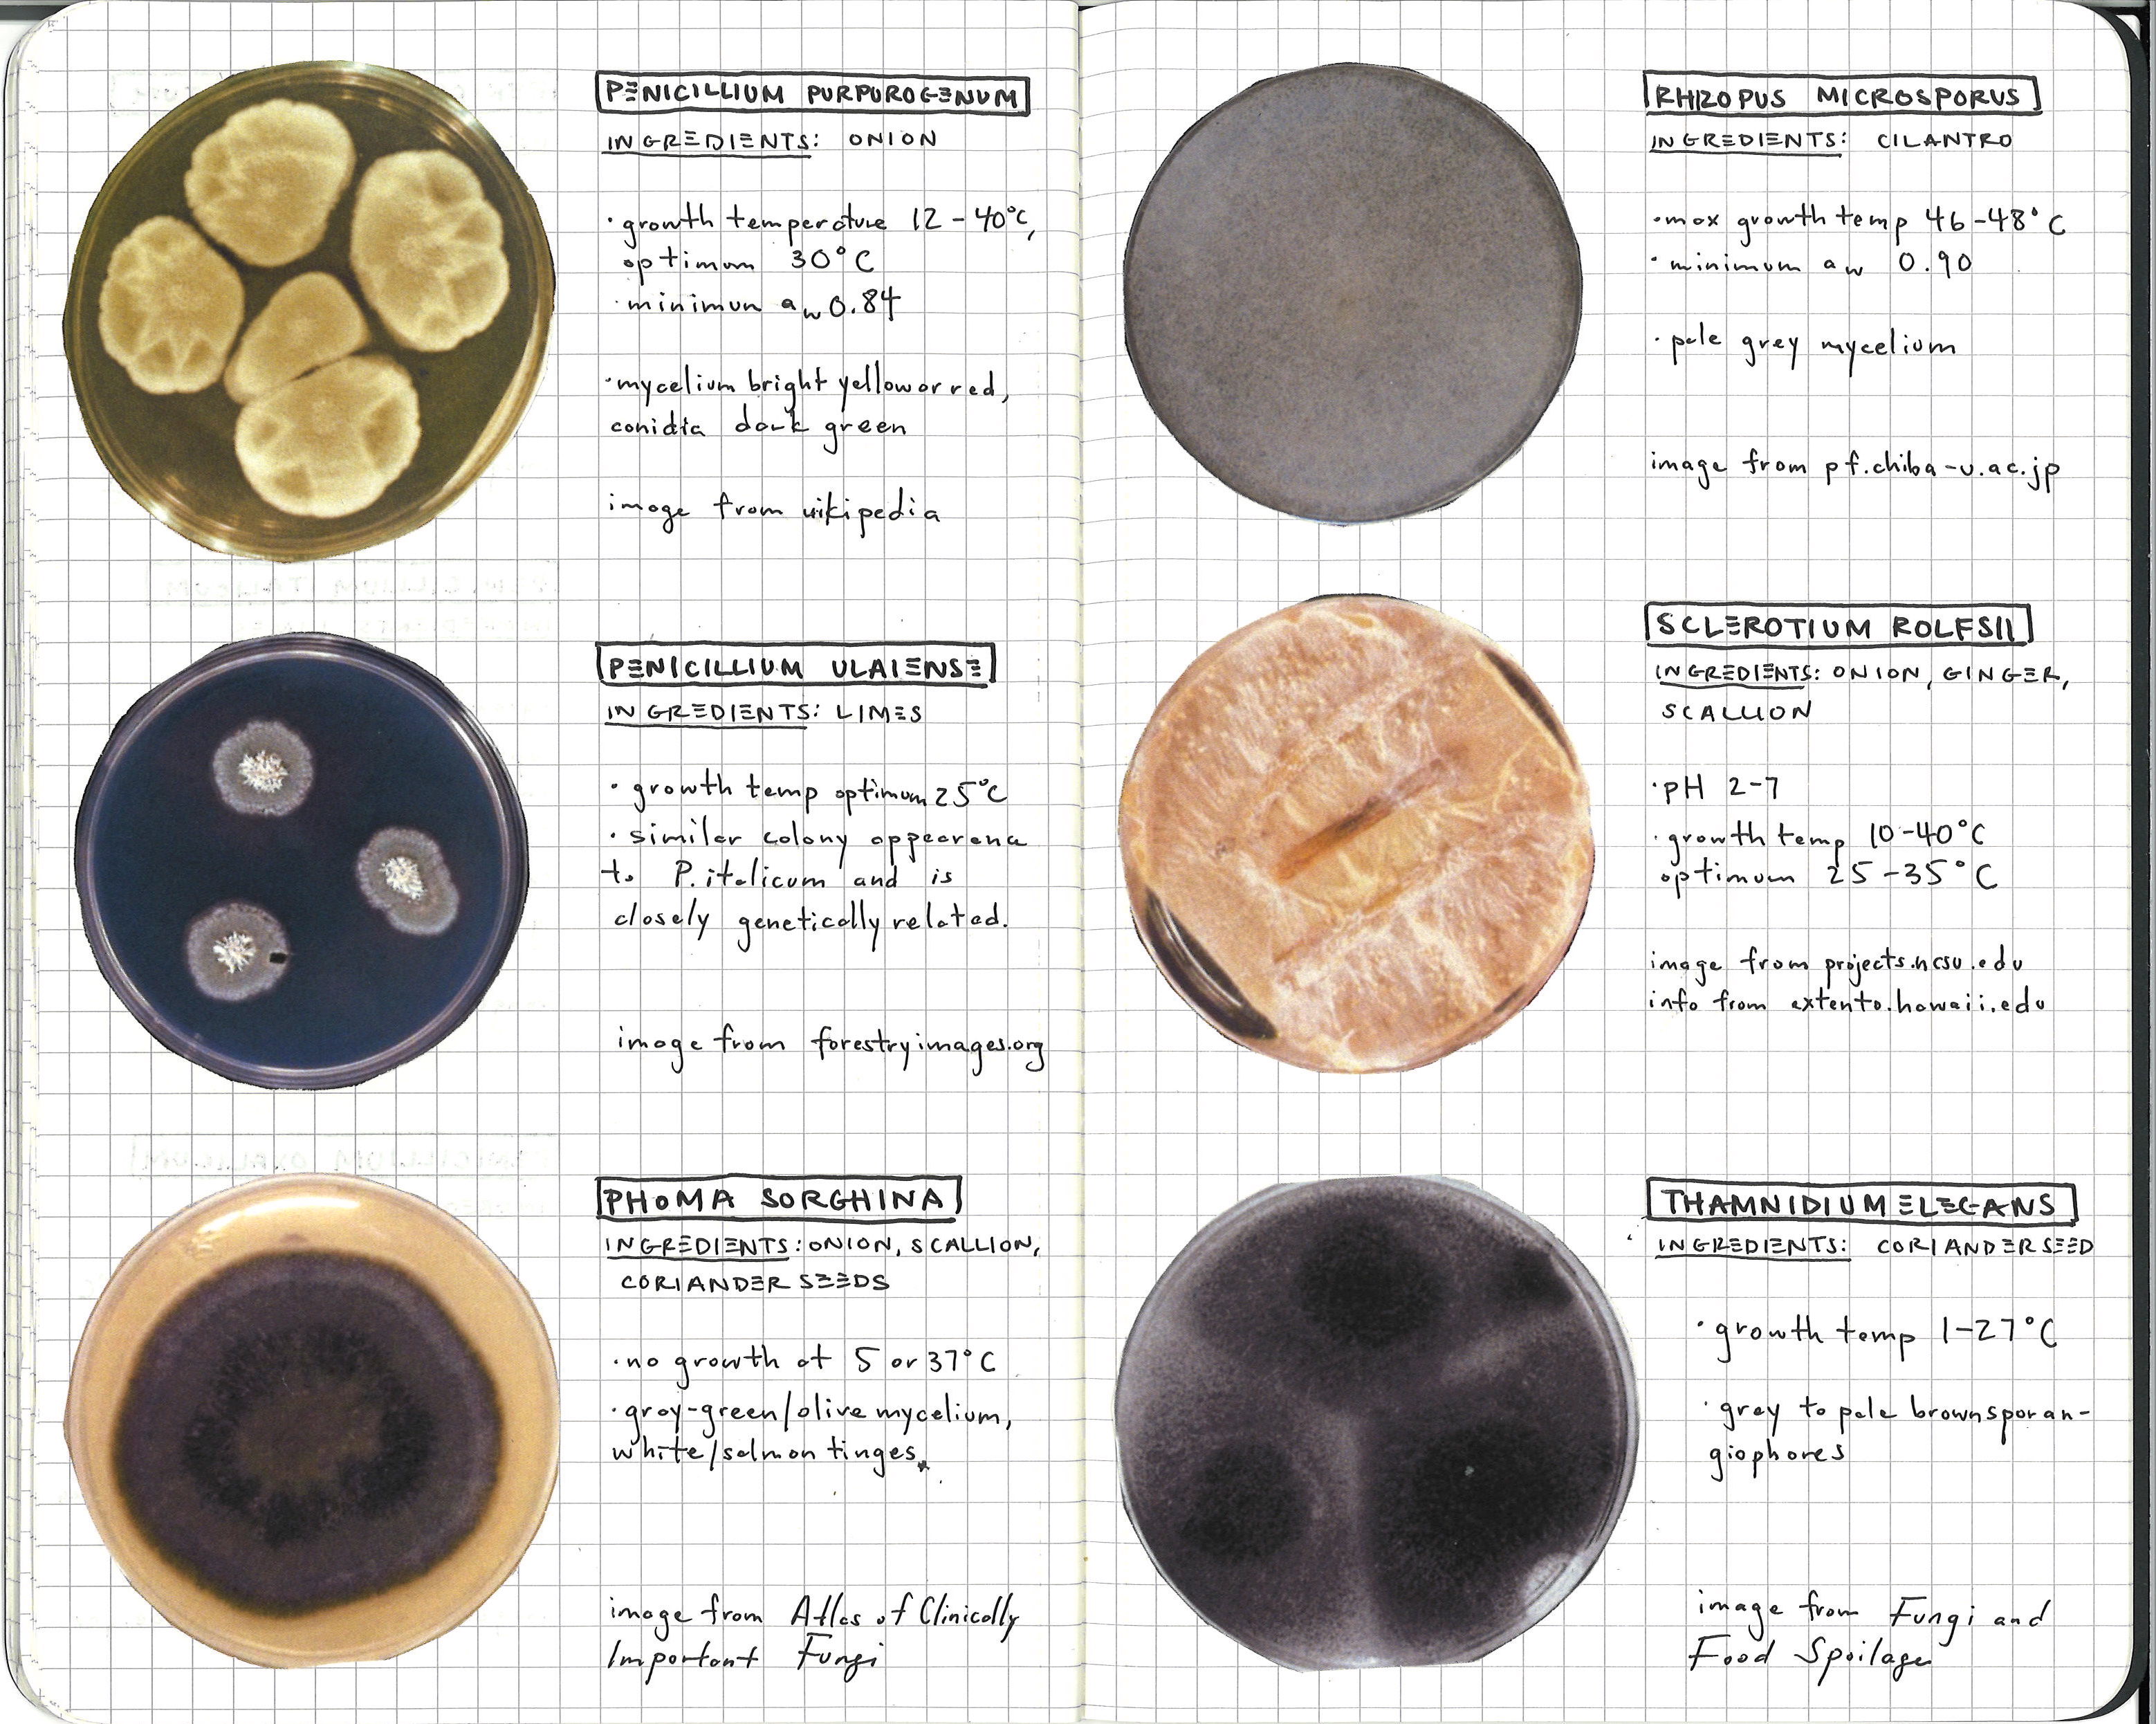

Craft Ecologies: Moldability
By RONAN REGENCIA NGHECraft Ecologies is an exploratory exhibition hosted by Viral Ecologies. Through this exhibition,11 undergraduate students from the course Knowledge Lab at the School of the Art Institute of Chicago, look closely at the complex systems that bring material into being.